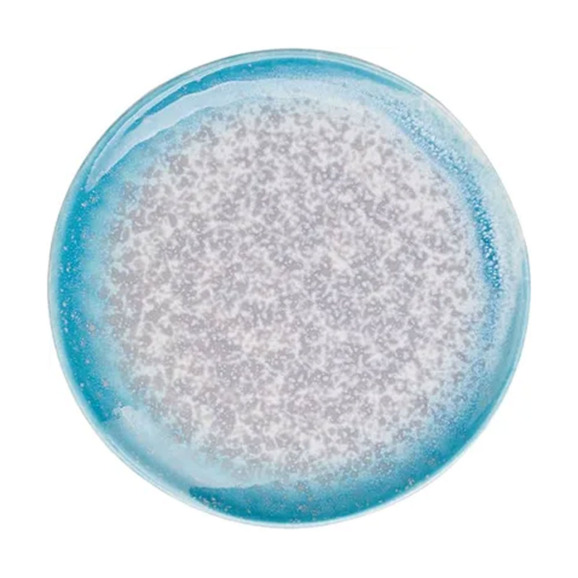

Характеристики товара
Описание
Продукция может поставляться в разобранном виде, уточняйте у менеджера.
Основные характеристики
- Высота15 мм
- Диаметр150 мм
- Вес0.245 кг
- Материалфарфор
- Цветбирюзовый
Параметры упаковки
- Количество изделий в упаковке12 шт
- Изделия стопируютсяНет